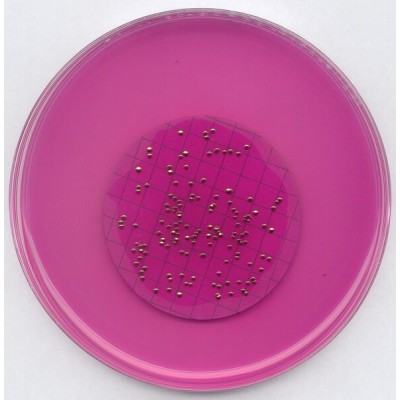
Los Angeles
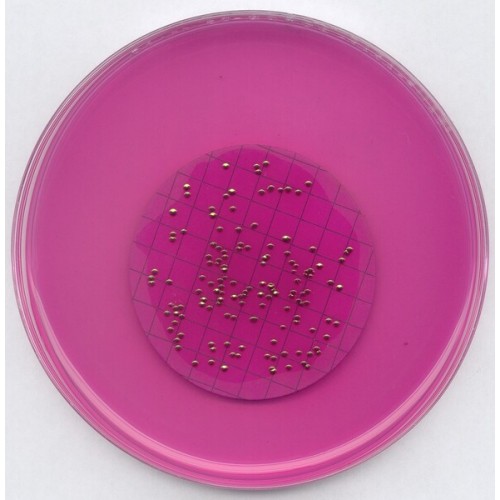

M-ENDO AGAR LES MERCK - 500g
Modelo: 1112770500
-
R$922,90
ou até 3x de R$307,63 sem juros
Economize 5% no PIX: R$876,76
ou 3.5% no boleto: R$890,60
Consulte aqui o valor do frete e prazo de entrega
Descrição
M ENDO AGAR LES MERCK
RENDIMENTO 51,0g/l SEG. COLIFORMES POR MF STANDARD METHODS
EMBALAGEM 500GR
Mode of Action
Growth of coliform bacteria is promoted by the selection of versatile nutrient bases. The accompanying flora is inhibited by lauryl sulfate and deoxychlolate. Lactose-positive colonies are coloured red due to the liberation of fuchsin from fuchsin-sulfite compound; E. coli colonies have a metallic sheen.
Typical Composition (g/litre)
Yeast extract 1.2;
casein hydrolysate 3.7;
peptone from meat 3.7;
tryptose 7.5; lactose 9.4;
di-potassium hydrogen phosphate 3.3;
potassium hydrogen phosphate 1.0;
sodium chloride 3.7;
sodium deoxycholate 0.1;
sodium lauryl sulfate 0.05;
sodium sulfite 1.6;
pararosanilin (fuchsin) 0.8;
agar-agar 15.0
Preparation
Suspend 51 g in 1 litre of distilled or deionized water containing 20 ml of ethanol 96 % and heat to boiling to dissolve completely. Do not autoclave! Cool to 45-50 °C. Dispense 4 ml amounts into Petridishes (Æ 50-60 mm) and allow to solidify. Cool to 50°C and pour plates.
pH: 7.2 ± 0.2 at 25 °C.
The plates are opalescent and red.
RENDIMENTO 51,0g/l SEG. COLIFORMES POR MF STANDARD METHODS
EMBALAGEM 500GR
Mode of Action
Growth of coliform bacteria is promoted by the selection of versatile nutrient bases. The accompanying flora is inhibited by lauryl sulfate and deoxychlolate. Lactose-positive colonies are coloured red due to the liberation of fuchsin from fuchsin-sulfite compound; E. coli colonies have a metallic sheen.
Typical Composition (g/litre)
Yeast extract 1.2;
casein hydrolysate 3.7;
peptone from meat 3.7;
tryptose 7.5; lactose 9.4;
di-potassium hydrogen phosphate 3.3;
potassium hydrogen phosphate 1.0;
sodium chloride 3.7;
sodium deoxycholate 0.1;
sodium lauryl sulfate 0.05;
sodium sulfite 1.6;
pararosanilin (fuchsin) 0.8;
agar-agar 15.0
Preparation
Suspend 51 g in 1 litre of distilled or deionized water containing 20 ml of ethanol 96 % and heat to boiling to dissolve completely. Do not autoclave! Cool to 45-50 °C. Dispense 4 ml amounts into Petridishes (Æ 50-60 mm) and allow to solidify. Cool to 50°C and pour plates.
pH: 7.2 ± 0.2 at 25 °C.
The plates are opalescent and red.
Etiquetas: meio de cultura, meio de cultura, agar, m-endo, LES,